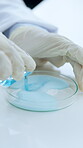
Hands, scientist and chemistry with petri dish in lab for healthcare, experiment and testing reaction. Gloves, salt or chemical observation of medical study, solution mixing and pharmaceutical sample

Stock Photo - Formula, glass wall and writing with man in laboratory for scientific education or study. Development, explain and solution with science team at work on clinical trial or pharmaceutical innovation
Formula, glass wall and writing with man in laboratory for scientific education or study. Development, explain and tablet with science team at work on medical research or pharmaceutical solution - Stock Photo